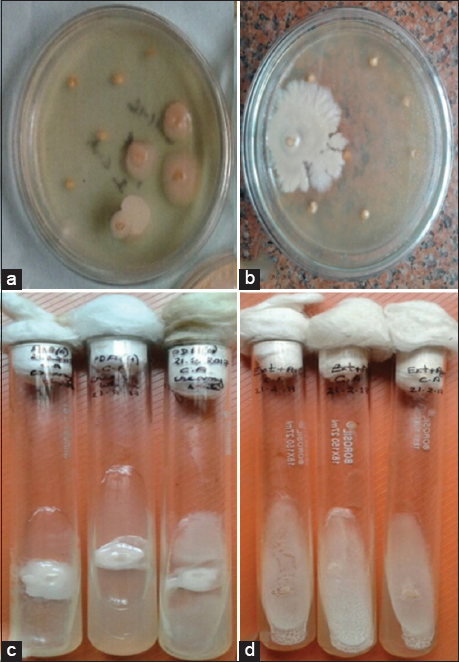

1. INTRODUCTION
Non-pathogenic endophytes are a type of microbe that lives in the internal tissues of living plants without causing any obvious harm to the host plant [1,2]. From recent studies, it was observed that endophytic microbes are widely distributed and may be able to colonize all classes of plants from where they can be isolated [3,4]. In general, endophytic microorganisms include fungi, bacteria, archaebacteria, and protists, which may play a crucial role in the metabolic processes as well as in physiological activities such as abiotic or biotic stress conditions in the host plant [5]. Endophytes typically engage in mutualistic or antagonistic interactions with their hosts, which may result in an obligatory or facultative association between the host plant and endophytes, resulting in a symbiotic to a slightly pathogenic association between them [6]. Fungi are the most prevalent endophytes in plants, primarily Ascomycetes, Deuteromycetes, and Basidiomycetes [7]. In general, plant vitality is greatly influenced by endophytes, which can also provide resistance to biotic or abiotic stress [8]. Furthermore, endophytes are a plentiful source of numerous vital metabolites, which explains why the modern industry, agriculture, and medicine are increasingly using them [9].
Yeasts are a unique subset of the symbiotic microflora within plants [10]. According to reports, yeast exists as an endophyte in a variety of plants and produces substances that contribute to the host plant’s growth improvement [11,12]. Even though they lack filamentous growth or flagella, they may have developed unique techniques for colonizing a plant [13]. Furthermore, due to their ease of culture, ability to be stored for a long time, and ability to be applied to crops, endophytic yeasts have a substantial advantage over other bacterial and filamentous endophytes [12]. In addition, yeast is also the source of several secondary metabolites, including phenols, flavonoids, stilbenoids, isoprenoids, sesquiterpenes, etc., with diverse industrial applications [14,15]. Some studies also suggest yeast’s crude extract contains significant metabolites that may function as antioxidants, anti-inflammatory agents, anti-proliferative agents, etc. [16]. Besides this, recent studies further indicate that endophytic yeast provides new insights for agricultural usage while also advancing our knowledge of plant microbiology and adaptation [17].
Plants with traditional medicinal value have played a great role in the hunt for new endophytes that may have multiple advantageous characteristics due to the activity of their metabolites [18]. It may be possible that the metabolites produced by their endophytic community may be the cause of their positive properties [19]. It was widely known that Capsicum annuum L., a significant traditional medicinal plant, not only plays a vital role as a magnificent host for a variety of endophytes, but it also had various therapeutic activities such as antioxidant, anti-inflammatory, and antibacterial. [20, 21]. The current study is focused on finding endophytes in C. annuum L. seed and determining their antimicrobial activity due to the species’ therapeutic characteristics.
2. MATERIALS AND METHODS
2.1. The Plant Material
For the investigation of the antimicrobial activity of yeast endophytes, seeds of C. annuum L. were selected as the source plant material. The plant material was collected from Manja town of Karbi Anglong district of Assam (25.83 N latitude, 93.83 E longitude, and 195 m altitude) [Figure 1a]. The climatic condition of this area makes it suitable for the excellent growth of all varieties of chilies. Healthy plants were selected from the vegetable garden, and ripe and healthy seeds from the fruits were collected for the study [Figure 1b-d]. The seeds were immediately wrapped with fresh banana leaves and kept in a plastic bag to avoid decay and moisture loss. The seeds were then transported to the laboratory within 24 h and stored at 4°C until the isolation procedure was completed.
 | Figure 1: Images of Capsicum annuum L. seeds and their inoculation; (a) Map of the study area (Karbi Anglong district); (b) C. annuum L. plant in natural habitat; (c) C. annuum L. fruits in the ripe stage; (d) Seeds of C. annuum L.; E-G = Inoculation of surface sterilized seeds in different media - Potato Dextrose Broth plate (e), Water Agar plate (f) and Host Extract + Agar plate (g). [Click here to view] |
2.2. Isolation of Endophytes
The endophytes were isolated from the seeds of C. annuum L. For the isolation process, the seeds were first washed under running tap water to remove any residue and then rinsed thoroughly with distilled water before surface sterilization. The seeds were then subjected to surface sterilization by dipping sequentially in 70% ethanol for 3 min and 0.5% sodium hypochlorite (NaOCl) for 1 min and were then transferred to a laminar airflow hood where they were rinsed thoroughly with sterile distilled water, and the excess water was dried out. The seed coat was removed, and the seeds were taken out with the help of a sterile needle and forceps and kept in sterile filter paper to dry again. A total of 150 seeds (50 seeds in each medium) were then inoculated on Petri plates using three different media, namely Potato Dextrose Agar (PDA), host extract + agar (HEA), and water agar (WA) [Figure 1e-g]. The plates were sealed with parafilm and incubated at 24±1°C for several days until the growth of the endophytes appeared on the plate [Figure 2a and b]. After incubation the endophytes growing out of the plated samples were removed with a fine, sterile needle and transferred to freshly prepared PDA and HEA slants, incubated for a few days and periodically checked for purity [Figure 2c and d]. The isolates were observed under the microscope for the typical moist appearance with smooth round colonies in the pure culture of yeasts, in contrast to the molds appearance of rough, dry colonies with aerial hyphae. The identified yeast isolates were again inoculated in a PDA medium from the slant by streaking method, and the pure yeast isolates obtained were then preserved at 4°C for further study.
| Figure 2: Isolation of endophytes; (a) Potato Dextrose Broth (PDB) medium; (b) Host Extract + Agar (HEA) media; (c and d) Pure culture of endophyte isolates; (c) PDB and (d) HEA media. [Click here to view] |
2.3. Yeast Cultivation
The selected yeast isolates were inoculated on PDA media using the streaking method and incubated for a few days. After incubation, the yeast endophytes were cultivated on a flask (250 mL) containing 100 mL Potato Dextrose Broth (PDB) and incubated again following shaking the media for 5–6 days. The flasks were kept under observation on a daily basis, and the yeast endophytes were evaluated for antimicrobial activity.
2.4. Test Organisms
Both Gram-positive and Gram-negative pathogenic bacteria were used as test organisms for the antimicrobial bioactivity assay of both the yeast endophyte and endophytic crude metabolites. The pathogenic Gram-positive bacteria include MTCC-736 (Bacillus subtilis), MTCC- 737 (Staphylococcus aureus) and the Gram-negative bacteria include MTCC- 424 (Pseudomonas aeruginosa). All the test organisms were procured from the Council of Scientific and Industrial Research- Institute of Microbial Technology (CSIR- IMTECH), Chandigarh, India. The bacterial strains were maintained on freshly prepared nutrient agar slants and stored at 4°C for further use.
2.5. Antimicrobial Activity Assay
The endophytic yeast obtained in pure culture were grown on PDB and incubated in a BOD incubator at 24 ± 1°C for 5–6 days. After the incubation time, 10% methanol was added to the fungus’ fermentation broth to homogenize it. Ethyl acetate and methanol were used as organic solvents in the solvent extraction technique to remove the metabolite. Equal amounts of the solvents were added to the filtrate, which was then thoroughly mixed for 10 min and left for 5 min to create two transparent, immiscible layers. Using a separating funnel, the solvent’s top layer that contained the extracted chemicals was separated. The crude metabolite was produced by evaporating the solvent and drying the resulting chemical in a rotator vacuum evaporator. After that, the crude extract was dissolved in 1 mg/mL dimethyl sulfoxide and stored at 4°C. The antimicrobial activity of the endophytic yeast was determined using crude metabolites from the yeast cultural broth by the Agar cup diffusion method of Grammer, 1976. It was followed by culturing of the yeast isolates that showed the highest zone of inhibition against the test pathogen using different concentrations (12.5%, 25%, 50%, and 100%) of PDB. The antimicrobial activity of the crude metabolite obtained from the cultural broth of the yeast isolates was determined by the agar cup diffusion method [22].
2.6. Data Analysis
The colonization frequency (CF) of endophytic yeast was calculated using the formula outlined by Hata and Futai [23].
 |
3. RESULTS
3.1. Isolation of Endophytic Fungi
Fresh and ripe seeds of C. annuum L. were selected for the endophytic study and were found to be colonized with yeast endophytes. Maximum endophytes were recovered in the PDA medium, followed by the HEA medium, and no endophytes were recovered in the WA medium. The number of yeast colonies isolated in the PDA medium was 32 and the HEA media was 8 [Table 1]. Altogether 40 numbers of yeast colonies were isolated, and the isolates represent six distinct colonies. The colonization frequencies of the six distinct isolates were studied. Among the isolates, isolate number CA3 was found to be the highest with a CF of 30%, followed by isolate numbers CA1 and CA5 with colonization frequencies of 20% and 14%, respectively [Table 2].
Table 1: Isolation of endophytic yeast from the seeds of C. annuum L. in different media.
| Media | No. of colonies |
|---|---|
| Potato Dextrose Agar | 32 |
| Water Agar | 0 |
| Host Extract+Agar | 08 |
Table 2: Colonization frequency of yeast endophytes in C. annuum L.
| Isolate No. | Colonization frequency (%) |
|---|---|
| CA1 | 20 |
| CA2 | 04 |
| CA3 | 30 |
| CA4 | 10 |
| CA5 | 14 |
| CA6 | 02 |
3.2. Antimicrobial Activities of Crude Metabolites Against Test Pathogen
The crude metabolites obtained from the culture broth of endophytic yeast grown aerobically on a PDB medium [Figure 3a], showed considerable antimicrobial activity against Gram-positive bacteria MTCC 737 (S. aureus) [Figure 3b] and no antimicrobial activity was observed against the pathogen MTCC 736 (B. subtilis) and MTCC 424 (P. aeruginosa) [Table 3]. Crude metabolites of the yeast isolate CA1 and CA5 showed a zone of antimicrobial activity where a larger zone was observed with CA5 crude metabolites and a smaller zone was observed with CA1 crude metabolites. No antimicrobial activity was observed with CA2, CA3, CA4, and CA6 crude metabolites. The antimicrobial activity was determined by the agar cup diffusion method.
 | Figure 3: Broth culture and antimicrobial activity analysis of yeast endophytes; (a) Yeast endophytes cultured in Potato Dextrose Broth medium and (b) Antimicrobial activity of the crude metabolites against MTCC 737 (Staphylococcus aureus) by agar cup diffusion method. [Click here to view] |
Table 3: Antimicrobial activity of crude metabolites of endophytic yeast isolates against some human pathogens.
| Test organism | Zone of inhibition (mm) | |||||
|---|---|---|---|---|---|---|
| CA1 | CA2 | CA3 | CA4 | CA5 | CA6 | |
| MTCC 424 | - | - | - | - | - | - |
| MTCC 736 | - | - | - | - | - | - |
| MTCC 737 | 12 mm | - | - | - | 16 mm | - |
-: Indicates no microbial activity; MTCC 424- P. aeruginosa; MTCC 736- B. subtilis; MTCC 737- S. aureus
The yeast isolates CA 1 and CA 5, which showed antimicrobial activity against the human pathogen, was cultured aerobically on different concentration of PDB medium (12.5%, 25%, 50%, and 100%) by streaking method [Table 4 and Figure 4a-c]. Considerable antimicrobial activity was observed against Gram-positive bacteria (B. subtilis and S. aureus) and no antimicrobial activity was observed in all the concentrations of PDB medium against Gram-negative bacteria MTCC 424 (P. aeruginosa) [Figure 4d-f]. Antimicrobial activity against the pathogen MTCC 736 (B. subtilis) was obtained with crude metabolites of CA1 grown on 50% PDB media, whereas no such activity was observed in other concentrations of PDB media. For MTCC 737 (S. aureus), antimicrobial activity was detected with the crude metabolites of CA1 grown on 12.5% and 25% PDB medium. Crude metabolites of CA1 yeast isolates grown on other concentrations of PDB medium showed no antimicrobial activity against MTCC 737 (S. aureus).
Table 4: Antimicrobial activity of endophytic yeast isolates CA1 in different concentrations of PDB medium against selected pathogens.
| Concentration of PDB media | Zone of inhibition (mm) | ||
|---|---|---|---|
| MTCC 424 | MTCC 736 | MTCC 737 | |
| PDB 100% | - | - | - |
| PDB 50% | - | + | - |
| PDB 25% | - | - | + |
| PDB 12.5% | - | - | + |
-: Indicates no microbial activity, +: Indicates microbial activity; PDB: Potato Dextrose Broth; MTCC 424- P. aeruginosa; MTCC 736- B. subtilis; MTCC 737- S. aureus
 | Figure 4: Pure culture of CA1 and CA2 isolates and their antimicrobial activity analysis; (a) Pure culture in Potato Dextrose Broth (PDA) medium; (b) CA1 culture in different concentration of PDB medium; (c) CA5 culture in different concentration of PDB medium; (d-f) Antimicrobial activity of crude metabolites of CA1 isolates from the different concentration of PDB medium against human pathogens; (g-i) Antimicrobial activity of crude metabolites of CA5 isolates from the different concentration of PDB medium against human pathogens. [Click here to view] |
Using the crude metabolites of CA5 yeast isolate, considerable antimicrobial activity was observed against Gram-negative bacteria MTCC 424 (P. aeruginosa) and Gram-positive bacteria MTCC 736 (B. subtilis) [Figure 4g-h]. The crude metabolite was studied for antimicrobial activity following the agar cup diffusion method [Table 5]. Antimicrobial activity against the pathogen MTCC 424 (P. aeruginosa) was detected with crude metabolites of CA5 grown on 12.5%, 25%, and 50% PDB media (a larger zone of antimicrobial activity is observed in 12.5% and 25%), but no activity was observed with PDB media concentration of 100%. On the other hand, antimicrobial activity against the pathogen MTCC 736 (B. subtilis) was detected in all concentrations of PDB medium (12.5%, 25%, 50%, and 100%), with the highest zone of inhibition being observed in 25% concentration of PDB media. However, no antimicrobial activity was detected against the pathogen MTCC 737 (S. aureus) with the crude metabolites of CA5 isolate grown in any concentration of the PDB medium [Figure 4i].
Table 5: Antimicrobial activity of endophytic yeast isolates, CA5 in different concentrations of PDB medium against selected pathogens.
| Concentration of PDB media | Zone of inhibition (mm) | ||
|---|---|---|---|
| MTCC 424 | MTCC 736 | MTCC 737 | |
| PDB 100% | - | + | - |
| PDB 50% | + | + | - |
| PDB 25% | ++ | ++ | - |
| PDB 12.5% | ++ | + | - |
-: Indicates no microbial activity, +: Indicates microbial activity; PDB: Potato Dextrose Broth, MTCC 424- P. aeruginosa; MTCC 736- B. subtilis; MTCC 737- S. aureus
From both the endophytic yeast isolates CA1 and CA5 in different concentration of PDB medium, different zone of antimicrobial activity has been detected against the selected pathogens. In comparison, isolate CA5 showed the highest activity against all the tested human pathogens than isolate CA1.
4. DISCUSSION
Endophytic microorganisms, particularly fungi, have the metabolic capacity to produce a wide range of bioactive compounds that can defend the plant against diseases, which is one of their most significant characteristics [24]. Furthermore, numerous studies had demonstrated that endophytic fungi bioactive substances have therapeutic effects against several plants and animal pathogens [19]. Therefore, it is necessary to isolate and identify endophytic microorganisms due to their medicinal properties [25]. In the present study, endophytes were isolated and identified from the medicinal plant C. annuum L. seeds, and their antimicrobial activity was assessed. The maximum number of endophytes were isolated from potato dextrose agar (PDA) media (32), followed by host extract + agar (8) which was identified as yeast endophyte. Furthermore, the seeds that were incubated on Water Agar media did not exhibit any endophytic growth. The growth of yeast endophytes was highest in the PDA medium may be due to the high concentration of dextrose, which fulfills the nutrient requirements for the growth of endophytic fungi [26]. Similar studies were also reported in Aegle marmelos (L.) Correa [27], Paullinia cupana Kunth [26], Olea europaea L. [26], and Triticum spp. [28] etc., where there is a considerable growth of endophytes was reported using PDA media.
A total of six distinct colonies of yeast (CA1-CA6) were identified, and the antimicrobial activity of their crude extract was examined. Among all six colonies, only the CA1 and CA5 colonies exhibit antimicrobial action, with CA5 displaying the strongest resistance to human pathogens. Similar observations were obtained in Vitex negundo L. [29], Eucalyptus spp. [30], Rafflesia cantleyi Solms [31], etc., where the metabolites of endophytes showed antimicrobial activity.
In addition, it was observed that different concentrations of PDB media affected the potency of antimicrobial activity of crude extract of the yeast isolates CA1 and CA5 against human pathogens. The CA1 showed activity against MTCC-736 (B. subtilis) (when cultured on 50% PDB) and MTCC-737 (S. aureus) (when cultured on 12.5% and 25% PDB). Also, CA5 showed activity against MTCC-736 (B. subtilis) (highest when cultured on 25% PDB) and MTCC-424 (P. aeruginosa) (highest when cultured on 12.5% and 25% PDB). This study demonstrates the differential resistance ability of the yeast isolates CA1 and CA5 against the test pathogens when grown on different concentrations of PDB media. To reveal the exact underlying cause of this activity, further study is preferred.
5. CONCLUSION
In the current study, yeast endophytes isolated from the seeds of C. annuum L. showed antimicrobial activity against some human pathogens. Specifically, endophytic yeast isolates CA1 and CA5 demonstrated the ability to produce bioactive agents against human pathogens. As C. annuum L. are known to have various medicinal properties, and the present preliminary study revealed the presence of endophytic fungi in the seeds which have beneficial properties, it may provide a new lead in the pursuit of new biological sources of drug candidates. Furthermore, our findings suggest that the ability of this plant’s endophytic microorganisms to produce biologically active secondary metabolites may be a contributing factor to its medicinal properties. More research is needed to identify the active compounds produced in order to discover new antibacterial drugs.
6. AUTHORS’ CONTRIBUTIONS
Barbi Bhuyan: Original draft preparation, investigation, writing, and editing.
Purthimi Kungri Hansepi: Investigation and writing.
Suraiya Akhtar: Writing, editing and visualization.
Raja Ahmed: Resources, writing and editing.
Kumanand Tayung: Conceptualization and supervision
Rafiul Amin Laskar: Editing and finalizing.
7. FUNDING
This research received no specific grant from any funding agency in the public, commercial, or not-for-profit sectors.
8. CONFLICTS OF INTEREST
The authors report no financial or any other conflicts of interest in this work.
9. ETHICAL APPROVALS
This study does not involve experiments on animals or human subjects.
10. DATA AVAILABILITY
All data generated and analyzed are included with in this research article.
11. PUBLISHER’S NOTE
This journal remains neutral with regard to jurisdictional claims in published institutional affiliation.
REFERENCES
1. Brader G, Compant S, Vescio K, Mitter B, Trognitz F, Ma LJ, et al. Ecology and Genomic insights into plant-pathogenic and plant-nonpathogenic endophytes. Annu Rev Phytopathol 2017;55:61-83. [CrossRef]
2. Zhang Q, White JF. Bioprospecting desert plants for endophytic and biostimulant microbes:A strategy for enhancing agricultural production in a hotter, drier future. Biology (Basel) 2021;10:961. [CrossRef]
3. Strobel GA. Microbial gifts of rain forests. Can J Plant Pathol 2002;24:14-20. [CrossRef]
4. Harrison JG, Griffin EA. The diversity and distribution of endophytes across biomes, plant phylogeny and host tissues:How far have we come and where do we go from here?Environ Microbiol 2020;22:2107-23. [CrossRef]
5. Hardoim PR, van Overbeek LS, Elsas JD. Properties of bacterial endophytes and their proposed role in plant growth. Trends Microbiol 2008;16:463-71. [CrossRef]
6. Fadiji AE, Babalola OO. Exploring the potentialities of beneficial endophytes for improved plant growth. Saudi J Biol Sci 2020;27:3622-33. [CrossRef]
7. Tayung K. Studies on Endophytic Microorganisms Associated with Taxus spp. Ph. D Thesis, Assam:Gauhati University;2008.
8. Balkrishna A, Sharma IP, Arya V, Sharma AK. Biologicals and their plant stress tolerance ability. Symbiosis 2022;86:243-59. [CrossRef]
9. Burragoni SG, Jeon J. Applications of endophytic microbes in agriculture, biotechnology, medicine, and beyond. Microbiol Res 2021;245:126691. [CrossRef]
10. MalassignéS, Minard G, Vallon L, Martin E, Valiente Moro C, Luis P. Diversity and functions of yeast communities associated with insects. Microorganisms 2021;9:1552. [CrossRef]
11. Luna EP. Endophytic yeast and hosts:A mutualistic association friendly to the environment. In:Lucas C, Pais C, editors. Old Yeasts-New Questions. London:IntechOpen;2017. 169-88. [CrossRef]
12. Joubert PM, Doty SL. Endophytic yeasts:Biology, ecology and applications. In:Pirttila A, Frank A, editors. Endophytes of Forest Trees. Berlin:Springer;2018. 3-14. [CrossRef]
13. Fu SF, Sun PF, Lu HY, Wei JY, Xiao HS, Fang WT, et al. Plant growth-promoting traits of yeasts isolated from the phyllosphere and rhizosphere of Drosera spatulata Lab. Fungal Biol 2016;120:433-48. [CrossRef]
14. Siddiqui MS, Thodey K, Trenchard I, Smolke CD. Advancing secondary metabolite biosynthesis in yeast with synthetic biology tools. FEMS Yeast Res 2012;12:144-70. [CrossRef]
15. Jahangeer M, Mahmood Z, Mashook A, Mehmood R, Munir N, Tahir IM, et al. Yeast cells secondary metabolites and their industrial applications;a review. Pak J Med Biol Sci 2019;2:62-7.
16. Silva FV, Souza GB, Nogueira AR. Use of yeast crude extract for sequential injection determination of carbohydrates. Anal Lett 2001;34:1377-88. [CrossRef]
17. Doty SL. Endophytic yeasts:Biology and applications. In:Aroca R, editor. Symbiotic Endophytes. Berlin:Springer;2013. 335-43. [CrossRef]
18. Khan AL, Gilani SA, Waqas M, Al-Hosni K, Al-Khiziri S, Kim YH, et al. Endophytes from medicinal plants and their potential for producing indole acetic acid, improving seed germination and mitigating oxidative stress. J Zhejiang Univ Sci B 2017;18:125-37. [CrossRef]
19. Dos Santos IP, da Silva LC, da Silva MV, de Araújo JM, Cavalcanti MS, Lima VL. Antibacterial activity of endophytic fungi from leaves of Indigofera suffruticosa Miller (Fabaceae). Front Microbiol 2015;6:350. [CrossRef]
20. Mantzoukas S, Lagogiannis I. Endophytic colonization of pepper (Capsicum annuum) controls aphids (Myzus persicae Sulzer). Appl Sci 2019;9:2239. [CrossRef]
21. Bacon K, Boyer R, Denbow C, O'Keefe S, Neilson A, Williams R. Antibacterial activity of jalapeño pepper (Capsicum annuum var. annuum) extract fractions against select foodborne pathogens. Food Sci Nutr 2017;5:730-8. [CrossRef]
22. Grammer A. Antibiotic sensitivity and assay test. In:Collins CH, Lyne PN, editors. Microbiological Methods. London:Butterworths;1976. 235.
23. Hata F, Futai K. Endophytic fungi associated with healthy pine needles and needles infested by pine needle gall midge Thecodiplosis japonensis. Can J Bot 1995;73:384-90. [CrossRef]
24. Abdel-Azeem AM, Abdel-Azeem MA, Khalil WF. Endophytic fungi as a new source of antirheumatoid metabolites. In:Watson RR, Preedy VR, editors. Bioactive Food as Dietary Interventions for Arthritis and Related Inflammatory Diseases. United States;Academic Press;2019. 355-84. [CrossRef]
25. Al-Ani LK. The importance of endophytic fungi from the medicinal plant:Diversity, natural bioactive compounds, and control of plant pathogens. In:Egamberdieva D, Tiezzi A, editors. Medically Important Plant Biomes:Source of Secondary Metabolites. Singapore:Springer;2019. 189-238. [CrossRef]
26. Sia EF, Marcon J, Luvizotto DM, Quecine MC, Tsui S, Pereira JO, et al. Endophytic fungi from the Amazonian plant Paullinia cupana and Olea europaea isolated using cassava as an alternative starch media source. SpringerPlus 2013;2:579. [CrossRef]
27. Mani VM, Soundari AP, Karthiyaini D, Preeth K. Bioprospecting endophytic fungi and their metabolites from medicinal tree Aegle marmelos in Western Ghats, India. Mycobiology 2015;43:303-10. [CrossRef]
28. Ripa FA, Cao WD, Tong S, Sun JG. Assessment of plant growth promoting and abiotic stress tolerance properties of wheat endophytic fungi. Biomed Res Int 2019;2019:6105865. [CrossRef]
29. Desale MG, Bodhankar MG. Antimicrobial activity of endophytic fungi isolated from Vitex negundo Linn. Int J Curr Microbiol App Sci 2013;2:389-95.
30. Sathish L, Pavithra N, Ananda K. Antimicrobial activity and biodegrading enzymes of endophytic fungi from Eucalyptus. Int J Pharm Sci Res 2012;3:2574-83.
31. Refaei J, Jones EB, Sakayaroj J, Santhanam J. Endophytic fungi from Rafflesia cantleyi:Species diversity and antimicrobial activity. Mycosphere 2011;2:429-47.